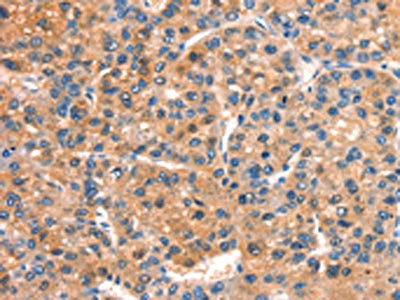

DOCK1 Antibody
-
中文名稱:DOCK1兔多克隆抗體
-
貨號:CSB-PA101358
-
規(guī)格:¥1100
-
圖片:
-
The image on the left is immunohistochemistry of paraffin-embedded Human liver cancer tissue using CSB-PA101358(DOCK1 Antibody) at dilution 1/25, on the right is treated with synthetic peptide. (Original magnification: ×200)
-
The image on the left is immunohistochemistry of paraffin-embedded Human gastric cancer tissue using CSB-PA101358(DOCK1 Antibody) at dilution 1/25, on the right is treated with synthetic peptide. (Original magnification: ×200)
-
-
其他:
產(chǎn)品詳情
-
Uniprot No.:
-
基因名:
-
別名:180 kDa protein downstream of CRK antibody; Ced5 antibody; Dedicator of Cytokinesis 1 antibody; Dedicator of cytokinesis protein 1 antibody; DOCK 1 antibody; DOCK 180 antibody; DOCK1 antibody; DOCK1_HUMAN antibody; DOCK180 antibody
-
宿主:Rabbit
-
反應(yīng)種屬:Human,Mouse
-
免疫原:Synthetic peptide of Human DOCK1
-
免疫原種屬:Homo sapiens (Human)
-
標(biāo)記方式:Non-conjugated
-
抗體亞型:IgG
-
純化方式:Antigen affinity purification
-
濃度:It differs from different batches. Please contact us to confirm it.
-
保存緩沖液:-20°C, pH7.4 PBS, 0.05% NaN3, 40% Glycerol
-
產(chǎn)品提供形式:Liquid
-
應(yīng)用范圍:ELISA,IHC
-
推薦稀釋比:
Application Recommended Dilution ELISA 1:1000-1:2000 IHC 1:25-1:100 -
Protocols:
-
儲存條件:Upon receipt, store at -20°C or -80°C. Avoid repeated freeze.
-
貨期:Basically, we can dispatch the products out in 1-3 working days after receiving your orders. Delivery time maybe differs from different purchasing way or location, please kindly consult your local distributors for specific delivery time.
-
用途:For Research Use Only. Not for use in diagnostic or therapeutic procedures.
相關(guān)產(chǎn)品
靶點(diǎn)詳情
-
功能:Involved in cytoskeletal rearrangements required for phagocytosis of apoptotic cells and cell motility. Along with DOCK1, mediates CRK/CRKL regulation of epithelial and endothelial cell spreading and migration on type IV collagen. Functions as a guanine nucleotide exchange factor (GEF), which activates Rac Rho small GTPases by exchanging bound GDP for free GTP. Its GEF activity may be enhanced by ELMO1.
-
基因功能參考文獻(xiàn):
- High DOCK1 expression is associated with Oral squamous cell carcinoma. PMID: 29286141
- Dock1 modulation by miR-31 plays an important function in glioma invasion PMID: 26946516
- In summary, this investigation identifies an EGFR-DOCK180-RAC1-MLK3-JNK signaling axis that drives glioblastoma cell migration and dissemination.IMPLICATIONS: On the basis of these findings, MLK3 emerges as a potential therapeutic target for the treatment of glioblastoma PMID: 28487380
- one statistically significant common variant in the DOCK1 gene was associated with DeltaBMI in GI cancer and COPD cases providing support for at least partially shared aetiology of DeltaBMI in complex diseases. PMID: 28044437
- Taken together, these results indicate that DOCK1 is a critical regulator of the malignant phenotypes induced by Rac1(P29S), and suggest that targeting DOCK1 might be an effective approach to treat cancers associated with Rac1(P29S) mutation. PMID: 29432733
- Data suggest that GPR124 promotes cell adhesion via interaction with Elmo1-Dock180 and intersectin 1/2; this constitutes a previously unrecognized heteromeric complex that is putatively involved in GPR124-dependent adhesive/angiogenic responses in vascular endothelial cells. (GPR124 = G-protein coupled receptor 124; Elmo1 = ELMO domain-containing protein 1; Dock180 = dedicator of cytokinesis protein 1 180 kDa) PMID: 28600358
- stimulation of the DOCK180 pathway represents an alternative mechanism of PTP1B inhibitor-stimulated endothelial cell motility, which does not require concomitant VEGFR2 activation as a prerequisite. PMID: 27052191
- Thus, Elmo1 and Dock180 facilitate blood vessel formation by stabilization of the endothelium during angiogenesis. PMID: 25586182
- High DOCK180 expression is associated with serous ovarian cancer. PMID: 24819662
- our findings describe a novel mechanism by which EGFRvIII drives glioma tumorigenesis and invasion through protein kinase A-dependent phosphorylation of Dock180 PMID: 23728337
- findings indicate that a chemokine-controlled pathway, consisting of Galphai2, ELMO1/Dock180, Rac1 and Rac2, regulates the actin cytoskeleton during breast cancer metastasis PMID: 23591873
- Dock180 could act as a pro-survival molecule in H9C2 cardiomyocytes via activation of its downstream pro-survival signaling molecule, AKT. PMID: 23314417
- Solved is the solution structure of DOCK180 SH3 domain, which shares similar target binding features with the SH3 domain of DOCK2. PMID: 23239367
- DOCK1-Rac signaling as an HER2 effector pathway essential for HER2-mediated breast cancer progression to metastasis. PMID: 23592719
- Phosphorylation of Dock180(Y1811) enhanced its association with CrkII & p130(Cas). Dock180 associated with PDGFRalpha to promote cell migration. Phosphorylated Dock180(Y1811) contributes to activation of Rac1 in human cancers with PDGFRA amplification. PMID: 22080864
- EGFRvIII (also known as DeltaEGFR and de2-7EGFR), a constitutively active EGFR mutant that is frequently co-overexpressed with EGFR in human glioblastoma, promotes tumorigenesis through Src family kinase (SFK)-dependent phosphorylation of Dock180 PMID: 22323579
- Dock180 contributes to ovarian carcinogenesis and dissemination PMID: 22175896
- DOCK180, an atypical Rac activator, links CXCR4 signaling to Rac activation in order to control endothelial cell migration during cardiovascular development. PMID: 20829512
- protein-protein interaction mediated by ARNO coiled-coil domain required for ARNO induced motility; coiled-coil domain promotes assembly of multiprotein complex containing ARNO and Dock180; assembly of complex requires coiled-coil domain, GRASP and IPCEF PMID: 20016009
- Dock180 ELMO complex functions as an unconventional two-part exchange factor for Rac. PMID: 12134158
- identification of an evolutionarily conserved superfamily of DOCK180-related proteins with guanine nucleotide exchange activity PMID: 12432077
- Rac activation by the ELMO.Dock180 complex at discrete intracellular locations mediated by the N-terminal 330 amino acids of ELMO1 plays a role in cell migration PMID: 14638695
- The N-terminal SH3 domain of Dock180 binds to the distant catalytic Docker domain and negatively regulates the function of Dock180. PMID: 15723800
- DOCK180, via its DHR-1 and DHR-2 domains, couples PtdIns(3,4,5)P(3) signalling to Rac GTP-loading, which is essential for directional cell movement. PMID: 16025104
- ARNO and ARF6 coordinate with the Dock180/Elmo complex to promote Rac activation at the leading edge of migrating cells. PMID: 16213822
- The DOCK180 protein is ubiquitylated on the plasma membrane, and also that Elmo1 functions as an inhibitor of ubiquitylation of Dock180. PMID: 16495483
- Using pulldown assays, we identified engulfment and cell motility (ELMO) protein as the IpgB1 binding partner. IpgB1 colocalized with ELMO and Dock180 in membrane ruffles induced by Shigella. PMID: 17173036
- A significant percentage of the total endogenous Crk II partitions in the nucleus in mammalian cells, where it forms distinct complexes with DOCK180, Wee1, and Abl. PMID: 17764157
- DOCK180 regulates CI-MPR trafficking via SNX5 and this function is independent of its guanine nucleotide exchange factor activity toward Rac1 PMID: 18596235
- The DOCK180-ELMO1 interaction is mapped to the N-terminal 200 amino acids of DOCK180, and to the C-terminal 200 amino acids of ELMO1, comprising the ELMO1 PH domain. PMID: 18768751
- ANKRD28, a novel binding partner of DOCK180, promotes cell migration by regulating focal adhesion formation. PMID: 19118547
- It regulates cell morphology and motility. (review) PMID: 19803396
顯示更多
收起更多
-
亞細(xì)胞定位:Cytoplasm. Membrane.
-
蛋白家族:DOCK family
-
組織特異性:Highly expressed in placenta, lung, kidney, pancreas and ovary. Expressed at intermediate level in thymus, testes and colon.
-
數(shù)據(jù)庫鏈接:
Most popular with customers
-
-
YWHAB Recombinant Monoclonal Antibody
Applications: ELISA, WB, IHC, IF, FC
Species Reactivity: Human, Mouse, Rat
-
Phospho-YAP1 (S127) Recombinant Monoclonal Antibody
Applications: ELISA, WB, IHC
Species Reactivity: Human
-
-
-
-
-